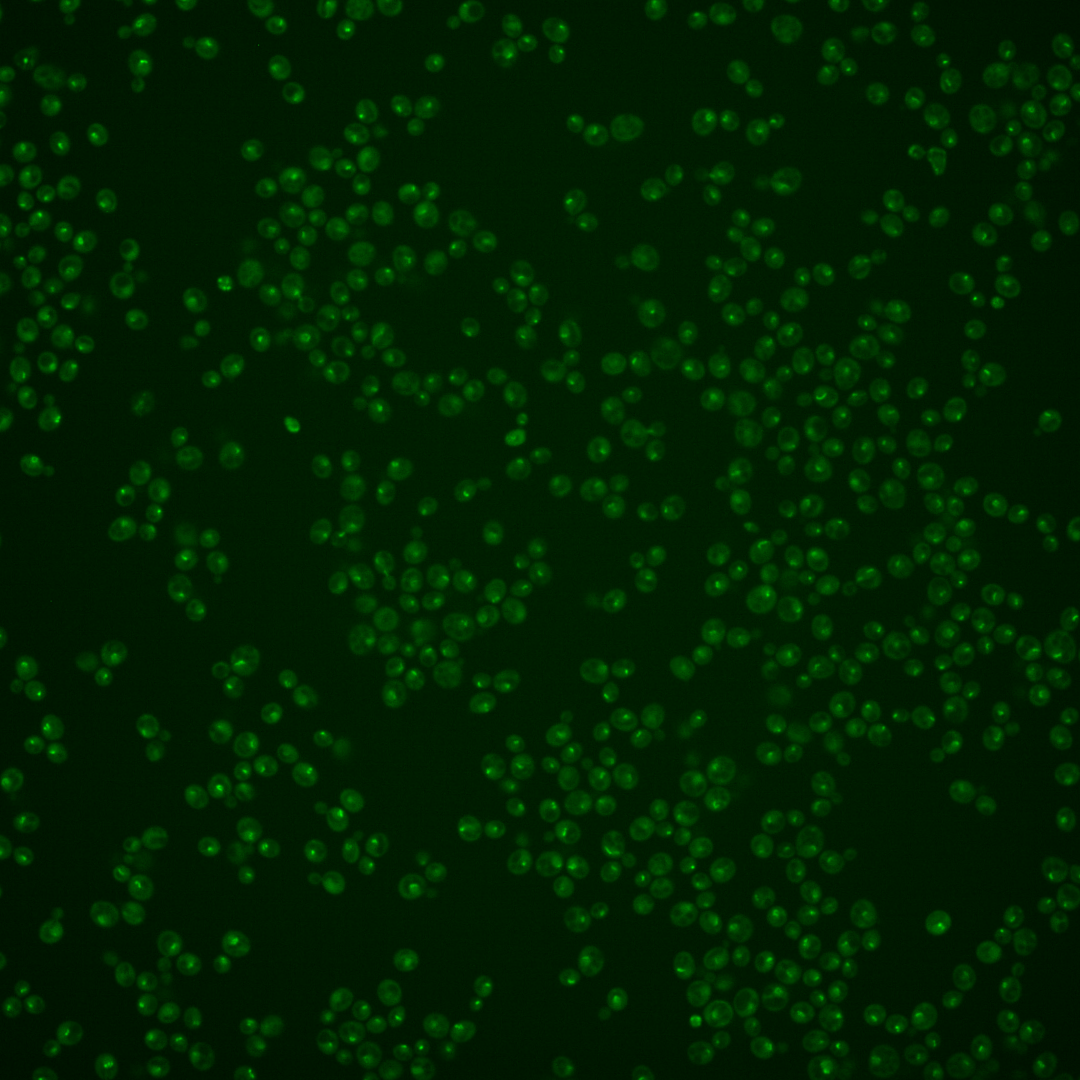
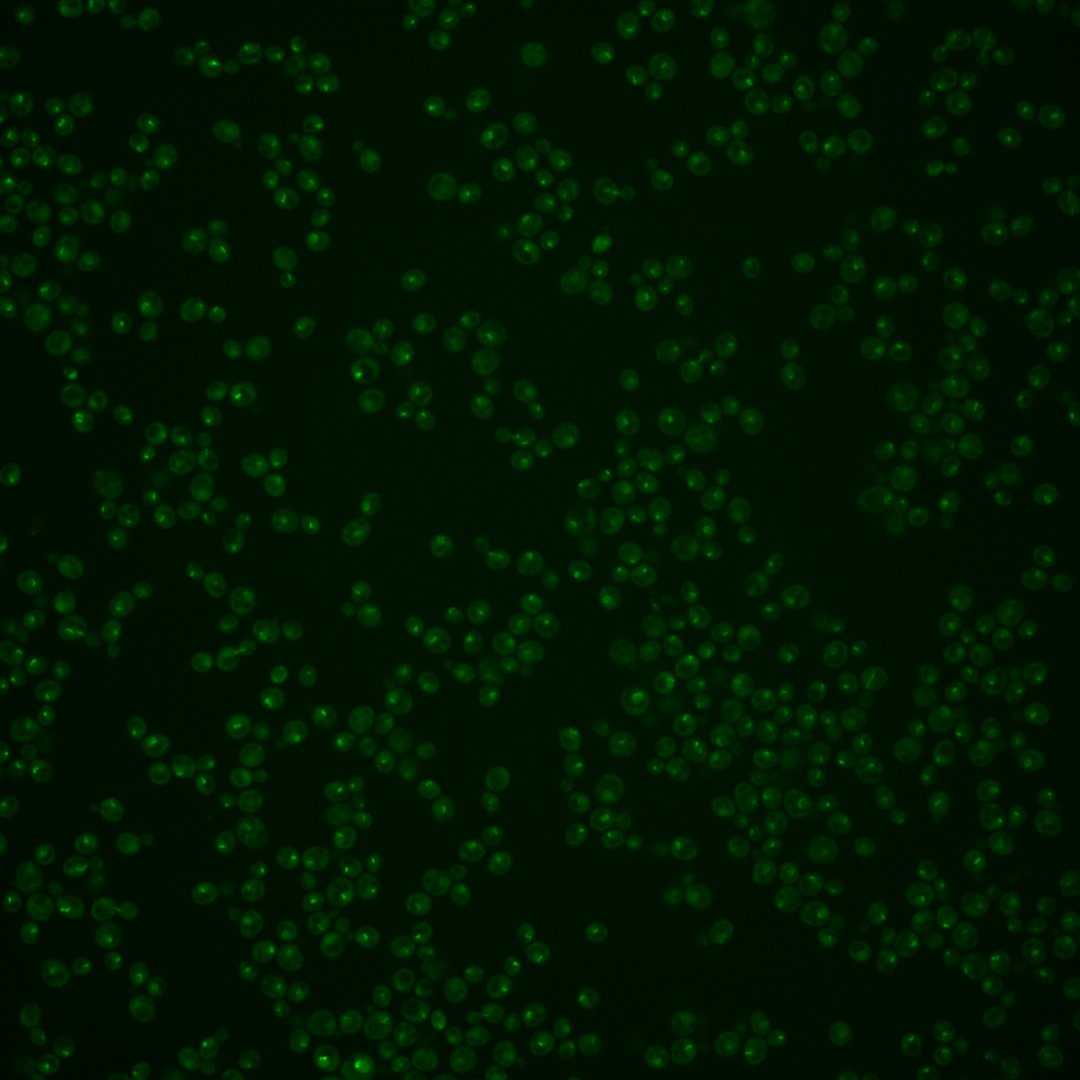
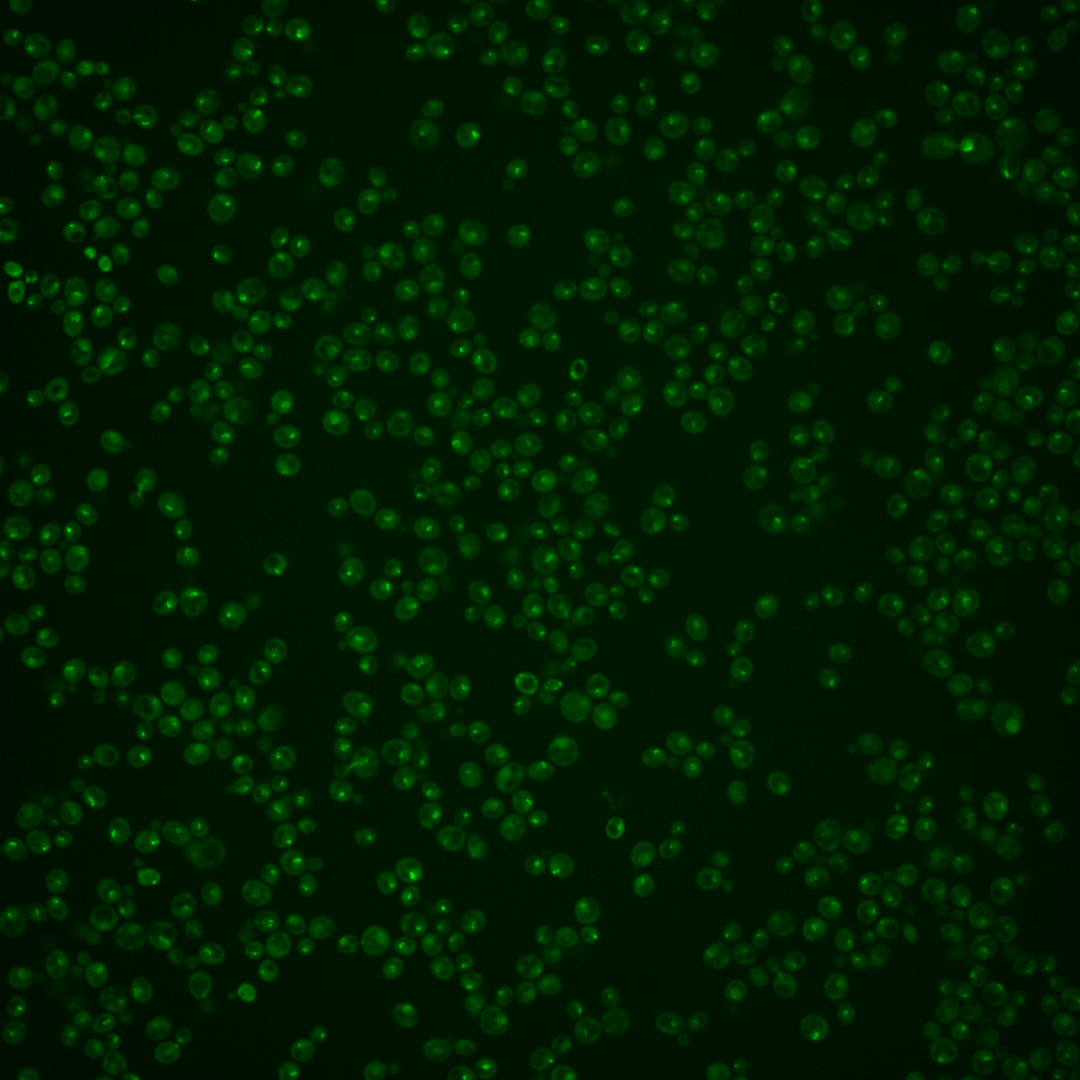

| Standard name | |
|---|---|
| Human Ortholog | |
| Description | Subunit of UAF (upstream activation factor) complex; UAF is an RNA polymerase I specific transcription stimulatory factor composed of Uaf30p, Rrn5p, Rrn9p, Rrn10p, histones H3 and H4; targeting factor for the UAF that facilitates activation of many rDNA genes; deletion decreases cellular growth rate; UAF30 has a paralog, TRI1, that arose from the whole genome duplication |
Micrographs




















































































Sub-cellular Localization
Yeast GFP Assignment
Protein Abundance
Localization Change
External localization resources
| ensLOC | DeepLoc | |||||||||||||||||||||||
|---|---|---|---|---|---|---|---|---|---|---|---|---|---|---|---|---|---|---|---|---|---|---|---|---|
| Localization | WT1 | WT2 | WT3 | RAP60 | RAP140 | RAP220 | RAP300 | RAP380 | RAP460 | RAP540 | RAP620 | RAP700 | HU80 | HU120 | HU160 | rpd3Δ_1 | rpd3Δ_2 | rpd3Δ_3 | WT1 | WT2 | WT3 | AF100 | AF140 | AF180 |
| Cortical Patches | 0 | 0 | 0 | 1 | 2 | 0 | 0 | – | 0 | 0 | 1 | 0 | 0 | 0 | 0 | 0 | 0 | 0 | 0 | 0 | 0 | 0 | 0 | 0 |
| Bud | 2 | 0 | 1 | 3 | 3 | 7 | 6 | – | 9 | 12 | 22 | 15 | 0 | 0 | 1 | 2 | 0 | 0 | 3 | 4 | 0 | 1 | 2 | 1 |
| Bud Neck | 7 | 0 | 8 | 16 | 42 | 18 | 24 | – | 27 | 29 | 19 | 26 | 8 | 7 | 11 | 0 | 1 | 3 | 2 | 2 | 1 | 3 | 1 | 6 |
| Bud Site | 4 | 1 | 0 | 6 | 0 | 8 | 7 | – | 7 | 27 | 27 | 25 | 1 | 1 | 0 | 3 | 0 | 3 | – | – | – | – | – | – |
| Cell Periphery | 0 | 0 | 0 | 0 | 0 | 0 | 0 | – | 0 | 0 | 0 | 0 | 0 | 0 | 0 | 0 | 0 | 0 | 0 | 0 | 0 | 0 | 0 | 0 |
| Cytoplasm | 4 | 7 | 3 | 14 | 28 | 16 | 39 | – | 12 | 29 | 19 | 22 | 16 | 46 | 54 | 70 | 39 | 43 | 0 | 3 | 0 | 2 | 3 | 5 |
| Endoplasmic Reticulum | 0 | 0 | 0 | 0 | 0 | 0 | 0 | – | 0 | 0 | 0 | 0 | 1 | 0 | 0 | 6 | 3 | 4 | 0 | 0 | 0 | 0 | 2 | 0 |
| Endosome | 35 | 35 | 1 | 8 | 14 | 0 | 10 | – | 3 | 3 | 5 | 14 | 37 | 57 | 45 | 23 | 20 | 17 | 36 | 21 | 15 | 18 | 29 | 27 |
| Golgi | 0 | 0 | 0 | 1 | 0 | 0 | 0 | – | 0 | 0 | 0 | 0 | 0 | 0 | 0 | 0 | 0 | 0 | 4 | 0 | 0 | 2 | 6 | 1 |
| Mitochondria | 41 | 40 | 3 | 3 | 4 | 27 | 21 | – | 48 | 72 | 85 | 81 | 4 | 5 | 3 | 19 | 12 | 15 | 5 | 2 | 0 | 1 | 2 | 3 |
| Nucleus | 29 | 37 | 15 | 28 | 24 | 10 | 32 | – | 15 | 25 | 26 | 17 | 25 | 24 | 18 | 22 | 16 | 21 | 7 | 18 | 4 | 2 | 3 | 2 |
| Nuclear Periphery | 2 | 1 | 2 | 0 | 0 | 0 | 0 | – | 1 | 0 | 0 | 0 | 4 | 0 | 1 | 3 | 1 | 0 | 3 | 0 | 0 | 0 | 0 | 0 |
| Nucleolus | 93 | 54 | 16 | 20 | 22 | 13 | 19 | – | 33 | 46 | 35 | 55 | 72 | 95 | 61 | 34 | 29 | 43 | 60 | 91 | 45 | 38 | 30 | 21 |
| Peroxisomes | 4 | 6 | 0 | 4 | 0 | 0 | 1 | – | 2 | 2 | 0 | 8 | 2 | 10 | 11 | 1 | 0 | 2 | 0 | 1 | 1 | 0 | 0 | 0 |
| SpindlePole | 66 | 81 | 82 | 118 | 222 | 60 | 180 | – | 136 | 193 | 176 | 236 | 105 | 164 | 108 | 53 | 51 | 50 | 87 | 71 | 60 | 87 | 134 | 112 |
| Vac/Vac Membrane | 2 | 5 | 1 | 1 | 2 | 1 | 1 | – | 2 | 1 | 2 | 1 | 1 | 1 | 0 | 7 | 7 | 11 | 4 | 10 | 1 | 3 | 4 | 5 |
| Unique Cell Count | 189 | 184 | 103 | 152 | 290 | 116 | 261 | 210 | 293 | 280 | 347 | 181 | 277 | 217 | 160 | 115 | 136 | 222 | 238 | 138 | 172 | 226 | 195 | |
| Labelled Cell Count | 289 | 267 | 132 | 223 | 363 | 160 | 340 | 295 | 439 | 417 | 500 | 276 | 410 | 313 | 243 | 179 | 212 | 222 | 238 | 138 | 172 | 226 | 195 | |
Yeast GFP Assignment
Protein Abundance
| Screen | WT1 | WT2 | WT3 | RAP60 | RAP140 | RAP220 | RAP300 | RAP380 | RAP460 | RAP540 | RAP620 | RAP700 | HU80 | HU120 | HU160 | rpd3Δ_1 | rpd3Δ_2 | rpd3Δ_3 | AF100 | AF140 | AF180 |
|---|---|---|---|---|---|---|---|---|---|---|---|---|---|---|---|---|---|---|---|---|---|
| Mean Cell GFP Intensity (1e-4) | 4.5 | 5.0 | 4.9 | 5.0 | 5.6 | 3.7 | 4.7 | – | 4.1 | 4.0 | 3.8 | 4.0 | 5.2 | 5.4 | 5.4 | 7.1 | 6.8 | 7.0 | 4.9 | 5.1 | 5.1 |
| Std Deviation (1e-4) | 1.0 | 0.9 | 0.9 | 1.5 | 1.4 | 1.3 | 1.8 | – | 1.3 | 1.2 | 1.0 | 1.1 | 0.9 | 1.6 | 1.7 | 2.1 | 1.8 | 1.8 | 1.7 | 1.6 | 1.6 |
| Intensity Change (Log2) | – | – | – | 0.03 | 0.19 | -0.41 | -0.06 | – | -0.27 | -0.29 | -0.36 | -0.29 | 0.1 | 0.14 | 0.15 | 0.54 | 0.48 | 0.53 | -0.0 | 0.06 | 0.06 |
Localization Change
| Localization | RAP60 | RAP140 | RAP220 | RAP300 | RAP380 | RAP460 | RAP540 | RAP620 | RAP700 | HU80 | HU120 | HU160 | rpd3Δ_1 | rpd3Δ_2 | rpd3Δ_3 |
|---|---|---|---|---|---|---|---|---|---|---|---|---|---|---|---|
| Cortical Patches | 0 | 0 | 0 | 0 | – | 0 | 0 | 0 | 0 | 0 | 0 | 0 | 0 | 0 | 0 |
| Bud | 0 | 0 | 0 | 0 | – | 0 | 0 | 0 | 0 | 0 | 0 | 0 | 0 | 0 | 0 |
| Bud Neck | 0.7 | 1.8 | 0 | 0 | – | 0 | 0 | 0 | 0 | -1.2 | 0 | -1.0 | 0 | 0 | 0 |
| Bud Site | 0 | 0 | 0 | 0 | – | 0 | 0 | 0 | 0 | 0 | 0 | 0 | 0 | 0 | 0 |
| Cell Periphery | 0 | 0 | 0 | 0 | – | 0 | 0 | 0 | 0 | 0 | 0 | 0 | 0 | 0 | 0 |
| Cytoplasm | 2.0 | 2.2 | 2.9 | 3.2 | – | 0 | 2.2 | 1.4 | 1.3 | 1.9 | 3.5 | 4.8 | 7.2 | 5.8 | 5.6 |
| Endoplasmic Reticulum | 0 | 0 | 0 | 0 | – | 0 | 0 | 0 | 0 | 0 | 0 | 0 | 0 | 0 | 0 |
| Endosome | 0 | 0 | 0 | 0 | – | 0 | 0 | 0 | 0 | 4.6 | 4.7 | 4.7 | 3.7 | 4.1 | 3.3 |
| Golgi | 0 | 0 | 0 | 0 | – | 0 | 0 | 0 | 0 | 0 | 0 | 0 | 0 | 0 | 0 |
| Mitochondria | 0 | 0 | 0 | 0 | – | 0 | 0 | 0 | 0 | 0 | 0 | 0 | 2.6 | 2.2 | 2.4 |
| Nucleus | 0.8 | -1.8 | -1.4 | -0.6 | – | -2.1 | -1.7 | -1.5 | -3.4 | -0.2 | -1.7 | -1.7 | -0.2 | -0.1 | 0.2 |
| Nuclear Periphery | 0 | 0 | 0 | 0 | – | 0 | 0 | 0 | 0 | 0 | 0 | 0 | 0 | 0 | 0 |
| Nucleolus | -0.5 | -2.3 | 0 | 0 | – | 0 | 0 | 0 | 0 | 4.2 | 3.6 | 2.5 | 1.2 | 1.8 | 2.9 |
| Peroxisomes | 0 | 0 | 0 | 0 | – | 0 | 0 | 0 | 0 | 0 | 0 | 0 | 0 | 0 | 0 |
| SpindlePole | -0.4 | -0.6 | 0 | 0 | – | 0 | 0 | 0 | 0 | -3.7 | -3.7 | -5.1 | -7.4 | -5.3 | -6.6 |
| Vacuole | 0 | 0 | 0 | 0 | – | 0 | 0 | 0 | 0 | 0 | 0 | 0 | 0 | 0 | 2.5 |
External localization resources
Images






























Protein Concentration and Protein Localization Data
| R1 | R2 | R3 | ||||||||||||||||
|---|---|---|---|---|---|---|---|---|---|---|---|---|---|---|---|---|---|---|
| G1 Pre-START | G1 Post-START | S/G2 | Metaphase | Anaphase | Telophase | G1 Pre-START | G1 Post-START | S/G2 | Metaphase | Anaphase | Telophase | G1 Pre-START | G1 Post-START | S/G2 | Metaphase | Anaphase | Telophase | |
| Concentration | -0.8113 | -0.5327 | -0.3854 | -0.9445 | -1.0488 | -0.6889 | 1.4785 | 1.1263 | 0.8426 | 1.2412 | 0.4554 | 0.9538 | 1.8625 | 2.1981 | 1.8041 | 1.9589 | 1.6934 | 1.7755 |
| Actin | 0.0368 | 0.0003 | 0.0124 | 0.004 | 0.0049 | 0.0009 | 0.0253 | 0.0027 | 0.0142 | 0.0212 | 0.0018 | 0.0009 | 0.0079 | 0.0001 | 0.0018 | 0.0001 | 0.0007 | 0.0002 |
| Bud | 0.0003 | 0.0003 | 0.0002 | 0.0005 | 0.0004 | 0.0001 | 0.0022 | 0.0006 | 0.0005 | 0.0008 | 0.0005 | 0.0002 | 0.0003 | 0.0001 | 0.0001 | 0.0002 | 0.0001 | 0.0001 |
| Bud Neck | 0.0039 | 0.0076 | 0.0077 | 0.0045 | 0.0083 | 0.0041 | 0.0063 | 0.0076 | 0.0096 | 0.0212 | 0.0855 | 0.0145 | 0.0094 | 0.004 | 0.0064 | 0.0215 | 0.0054 | 0.0086 |
| Bud Periphery | 0.0003 | 0.0006 | 0.0003 | 0.0007 | 0.0006 | 0.0001 | 0.0054 | 0.0008 | 0.0007 | 0.001 | 0.001 | 0.0005 | 0.0006 | 0.0002 | 0.0002 | 0.0004 | 0.0006 | 0.0003 |
| Bud Site | 0.0023 | 0.0051 | 0.0025 | 0.0017 | 0.0154 | 0.0005 | 0.0037 | 0.0151 | 0.0037 | 0.0113 | 0.0051 | 0.0021 | 0.0057 | 0.0015 | 0.0078 | 0.0024 | 0.0006 | 0.0008 |
| Cell Periphery | 0.0003 | 0.0008 | 0.0005 | 0.0003 | 0.0003 | 0.0001 | 0.0006 | 0.0006 | 0.0006 | 0.001 | 0.0003 | 0.0003 | 0.0007 | 0.0001 | 0.0005 | 0.0008 | 0.0002 | 0.0003 |
| Cytoplasm | 0.0028 | 0.0039 | 0.0028 | 0.0332 | 0.0008 | 0.0014 | 0.01 | 0.0029 | 0.0084 | 0.0127 | 0.0099 | 0.0014 | 0.0039 | 0.0002 | 0.0008 | 0.0012 | 0.0003 | 0.001 |
| Cytoplasmic Foci | 0.0945 | 0.0579 | 0.05 | 0.0371 | 0.0537 | 0.0366 | 0.0496 | 0.0372 | 0.0375 | 0.0342 | 0.0189 | 0.0221 | 0.0535 | 0.0153 | 0.0268 | 0.0424 | 0.0278 | 0.0233 |
| Eisosomes | 0.0002 | 0.0002 | 0.0003 | 0.0001 | 0.0002 | 0 | 0.0003 | 0.0001 | 0.0001 | 0.0001 | 0.0001 | 0 | 0.0004 | 0 | 0.0001 | 0.0001 | 0.0001 | 0.0001 |
| Endoplasmic Reticulum | 0.0009 | 0.0007 | 0.0011 | 0.0013 | 0.0003 | 0.0001 | 0.0016 | 0.0021 | 0.0009 | 0.006 | 0.0023 | 0.0006 | 0.0008 | 0.0001 | 0.0002 | 0.0002 | 0.0001 | 0.0054 |
| Endosome | 0.0223 | 0.0197 | 0.0245 | 0.0361 | 0.0096 | 0.0052 | 0.0549 | 0.0196 | 0.0184 | 0.0328 | 0.0172 | 0.0184 | 0.0162 | 0.0017 | 0.0106 | 0.0077 | 0.0055 | 0.0041 |
| Golgi | 0.0106 | 0.0052 | 0.02 | 0.0135 | 0.0073 | 0.0037 | 0.0333 | 0.0091 | 0.0109 | 0.0298 | 0.0091 | 0.0052 | 0.007 | 0.0014 | 0.0033 | 0.0025 | 0.0051 | 0.0025 |
| Lipid Particles | 0.2063 | 0.1714 | 0.1615 | 0.0843 | 0.1665 | 0.1145 | 0.1139 | 0.081 | 0.0888 | 0.1021 | 0.0598 | 0.0686 | 0.1564 | 0.0383 | 0.089 | 0.0847 | 0.1661 | 0.0717 |
| Mitochondria | 0.0016 | 0.0013 | 0.0194 | 0.0582 | 0.0034 | 0.0002 | 0.0389 | 0.0054 | 0.0031 | 0.0073 | 0.027 | 0.0007 | 0.0055 | 0.0002 | 0.0004 | 0.0012 | 0.0094 | 0.0003 |
| None | 0.0042 | 0.0133 | 0.0258 | 0.0232 | 0.0034 | 0.0009 | 0.038 | 0.0132 | 0.0024 | 0.0008 | 0.0046 | 0.0005 | 0.0164 | 0.0021 | 0.0015 | 0.0027 | 0.0009 | 0.0148 |
| Nuclear Periphery | 0.003 | 0.0035 | 0.013 | 0.0031 | 0.0022 | 0.004 | 0.0052 | 0.0022 | 0.0078 | 0.0036 | 0.0129 | 0.0063 | 0.0053 | 0.0019 | 0.0017 | 0.0004 | 0.0042 | 0.0025 |
| Nucleolus | 0.2123 | 0.3674 | 0.3702 | 0.4699 | 0.0894 | 0.2048 | 0.2101 | 0.4809 | 0.5185 | 0.489 | 0.2583 | 0.3255 | 0.2358 | 0.4321 | 0.4809 | 0.4515 | 0.2416 | 0.2111 |
| Nucleus | 0.0188 | 0.0353 | 0.0256 | 0.0358 | 0.0075 | 0.028 | 0.0505 | 0.0752 | 0.073 | 0.0399 | 0.0738 | 0.0283 | 0.0365 | 0.034 | 0.0443 | 0.0295 | 0.027 | 0.0209 |
| Peroxisomes | 0.0289 | 0.0074 | 0.0149 | 0.0056 | 0.0434 | 0.0099 | 0.0191 | 0.0071 | 0.0044 | 0.0048 | 0.0042 | 0.0065 | 0.0201 | 0.0027 | 0.0082 | 0.017 | 0.0472 | 0.0058 |
| Punctate Nuclear | 0.3468 | 0.2868 | 0.2431 | 0.1778 | 0.5802 | 0.5838 | 0.3134 | 0.2247 | 0.1858 | 0.1677 | 0.4017 | 0.4937 | 0.4136 | 0.4632 | 0.3104 | 0.3286 | 0.455 | 0.6245 |
| Vacuole | 0.0025 | 0.0103 | 0.0033 | 0.0054 | 0.0018 | 0.0008 | 0.0135 | 0.0109 | 0.0096 | 0.0117 | 0.0042 | 0.0031 | 0.0035 | 0.0007 | 0.0045 | 0.0046 | 0.0013 | 0.0016 |
| Vacuole Periphery | 0.0005 | 0.0009 | 0.001 | 0.0037 | 0.0005 | 0.0002 | 0.0041 | 0.001 | 0.0013 | 0.0012 | 0.0017 | 0.0005 | 0.0004 | 0.0001 | 0.0002 | 0.0003 | 0.0006 | 0.0002 |
Sequencing Data
| R1 | R2 | |||||||||
|---|---|---|---|---|---|---|---|---|---|---|
| G1 Post-START | S/G2 | Metaphase | Anaphase | Telophase | G1 Post-START | S/G2 | Metaphase | Anaphase | Telophase | |
| Gene Expression | 5.6214 | 4.3073 | 2.1308 | 9.3071 | 10.412 | 3.2105 | 9.4361 | 6.3687 | 10.4847 | 9.3928 |
| Translational Efficiency | 1.7034 | 2.3437 | 3.8698 | 1.0842 | 0.8862 | 3.1214 | 1.4302 | 1.5247 | 0.773 | 1.0627 |
Hit Data
| Dataset | Hit |
|---|---|
| Protein Concentration | ✘ |
| Protein Localization | ✔ |
| Gene Expression | ✘ |
| Translational Efficiency | ✘ |
Endocytosis
| Temp | Actin Patch (Sac6-tdTomato) | Cortical Patch (Sla1-GFP) | Late Endosome (Snf7-GFP) | Vacuole (Vph1-GFP) |
|---|---|---|---|---|
| 37℃ | ||||
| RT |
Cell Cycle Omics
CYCLoPs (Uaf30-GFP)
| Gene / Allele | Actin Patch (Sac6-tdTomato) | Cortical Patch (Sla1-GFP) | Late Endosome (Snf7-GFP) | Vacuole (Sac6-tdTomato) |
|---|
| Gene | Images |
|---|
| Gene | Images |
|---|
Images are not yet available
Images are not yet available